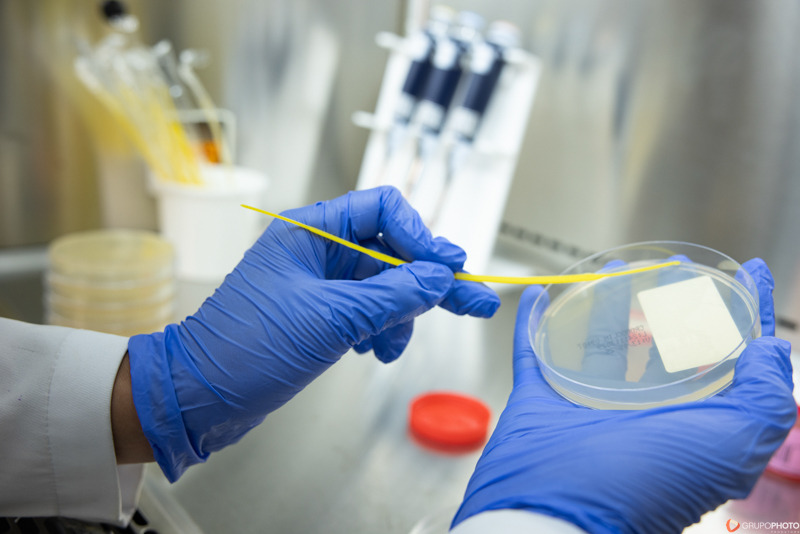

Em um projeto recente, tivemos a honra de realizar a sessão de fotografia institucional para o Hospital Sírio-Libanês, um dos maiores e mais respeitados hospitais do Brasil. O objetivo foi capturar imagens que pudessem refletir a seriedade e a dedicação do hospital em sua missão de oferecer cuidados de saúde de excelência, ao mesmo tempo em que destacam suas práticas de sustentabilidade.



A sessão de fotos envolveu diversos ambientes do hospital, incluindo áreas de atendimento, infraestrutura, e processos internos, sempre com um olhar atento aos detalhes que transmitem a responsabilidade ambiental e social do hospital. Cada clique foi pensado para complementar as informações do relatório de sustentabilidade, reforçando o compromisso do Sírio-Libanês com a transparência e a qualidade.

O trabalho realizado não só resultou em belas imagens, mas também proporcionou uma visão clara e impactante das iniciativas de sustentabilidade da instituição, importantes para engajar seus colaboradores, pacientes e a comunidade.



Se sua empresa também precisa de imagens institucionais que transmitam a seriedade e os valores da sua marca, entre em contato conosco. Estamos prontos para capturar a essência do seu negócio de forma única e profissional.








